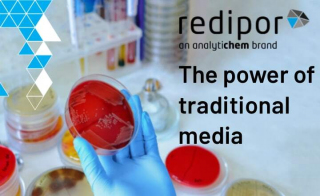
Rapid Microbial Detection Relies on the Power of Traditional Media

What's in a name? How important is microbial identification, and how can laboratories obtain the fast and accurate results they need? Proper identification remains fundamental to quality control microbiology, requiring robust systems from specimen collection through final analysis.
Specimen Collection and Transport Excellence
Puritan® transport systems provide comprehensive solutions with multiple media options, including dry transport and liquid formulations. These systems preserve specimen integrity during transit, ensuring accurate downstream identification processes.
In our expert insight series, we discover from Charles River when laboratories should choose protein-coding gene sequencing over ribosomal RNA methods, which is essential when dealing with closely related species that ribosomal RNA cannot reliably differentiate. This includes complex groups like Bacillus cereus, Burkholderia cepacia, and other taxonomically challenging organisms where species-level identification impacts clinical decisions.
How does MALDI-TOF MS compare to traditional biochemical identification methods? MALDI-TOF mass spectrometry delivers significantly faster results over traditional methods. It demonstrates better accuracy for stressed environmental strains and provides consistent, objective results that reduce operator variability. Pharmaceutical quality control workflows are transformed by MALDI-TOF mass spectrometry, as demonstrated by the VITEK® MS PRIME. Real-world applications at facilities like ACM Pharma showcase the system's ability to handle stressed environmental strains while maintaining the speed and reliability that modern laboratories demand.
Are traditional culture methods still necessary with advanced molecular techniques? Many identification workflows benefit from combining rapid molecular screening with selective culture media. For example, specialised identification systems like Microgen Listeria-ID enable laboratories to properly identify and differentiate Listeria species in food and environmental samples, providing complete identification capabilities without requiring additional materials.
The FDA's recent approval of Bruker's advanced MALDI Biotyper® features further validates this technology's clinical importance, with an expanded reference library now encompassing 549 clinically validated microbial species across gram-positive and gram-negative bacteria, anaerobes, and yeasts.
Next-generation sequencing platforms offer comprehensive genomic solutions for unknown bacterial and fungal isolates. Whole genome sequencing (WGS) serves as the ideal starting point when traditional identification methods fall short, providing complete genetic profiles that enable definitive species-level identification. Automated NGS platforms now deliver next-day identification directly from extracted DNA of specimens collected from normally sterile body sites, including cerebrospinal fluid, blood, tissue, and synovial fluid.
Explore the latest microbial identification solutions here in this rapidmicrobiology special focus - find the right one for your laboratory's specific application and workflow.
Find Out More
Find Out More
Find Out More
Find Out More
Find Out More
Find Out More
Find Out More
Find Out More
Find Out More
Find Out More